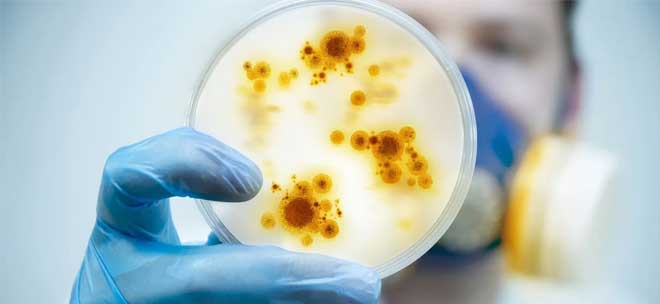

Με αφορμή τη δημόσια συζήτηση που εξελίσσεται γύρω από την ευλογιά των πιθήκων, ο ΕΟΔΥ κρίνει σκόπιμο να επισημάνει ότι ο στιγματισμός πολιτών ή συμπεριφορών δεν προάγει τη δημόσια υγεία, αλλά αντίθετα στιγματίζει συγκεκριμένες κοινωνικές ομάδες, οδηγώντας σε εφησυχασμό άλλες ομάδες πολιτών, με συνέπεια να αυξάνεται ο κίνδυνος για τη διασπορά λοιμωδών νοσημάτων.
Η ευλογιά των πιθήκων μπορεί να προσβάλει οποιοδήποτε άτομο και δεν αφορά, ούτε προέρχεται από συγκεκριμένες ομάδες πληθυσμού.
Οι τρόποι μετάδοσης της ευλογιάς των πιθήκων περιλαμβάνουν:
α. Στενή προσωπική επαφή
β. Έκθεση σε βιολογικά υγρά
γ. Επαφή με μολυσμένες επιφάνειες ή αντικείμενα (όπως κλινοσκεπάσματα, είδη ρουχισμού/ιματισμού)
Η ευλογιά των πιθήκων δεν μεταδίδεται αμιγώς σεξουαλικά, αλλά μπορεί να μεταδοθεί μέσω σεξουαλικής επαφής κατά τη σωματική επαφή.
Σε κάθε περίπτωση, τα λοιμώδη νοσήματα δεν γνωρίζουν σύνορα και δεν κάνουν διακρίσεις στη μετάδοσή τους. Γι’ αυτό τον λόγο, τα προληπτικά μέτρα συστήνονται ανεξαιρέτως για όλη την κοινότητα.
Παράλληλα, ανώτερη αξιωματούχος του Παγκόσμιου Οργανισμού Υγείας δήλωσε σήμερα ότι πρέπει να αποτελέσει προτεραιότητα η αναχαίτιση της ευλογιάς των πιθήκων στις χώρες όπου η νόσος αυτή δεν είναι ενδημική, διευκρινίζοντας ότι αυτό μπορεί να επιτευχθεί αν αναληφθεί γρήγορα δράση.
«Πιστεύουμε πως, αν πάρουμε τα σωστά μέτρα τώρα, μπορούμε να την αναχαιτίσουμε εύκολα», δήλωσε η Σιλβί Μπριάν, διευθύντρια του ΠΟΥ αρμόδια για την ετοιμότητα έναντι του κινδύνου από τις μολυσματικές νόσους.
 Health Update Health Update
Health Update Health Update